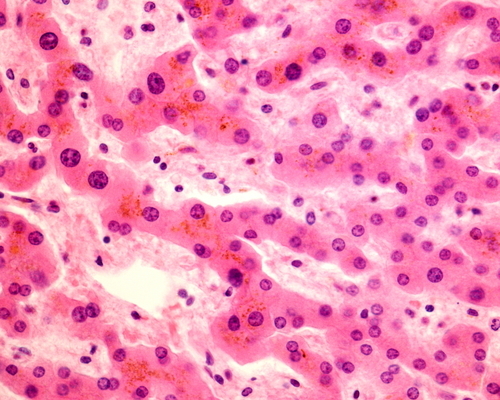

Study shows liver cells with whole genome duplications protect against cancer
UT Southwestern Medical Center Feb 11, 2018
Researchers at the Children’s Medical Center Research Institute (CRI) at UT Southwestern have discovered that cells in the liver with whole genome duplications, known as polyploid cells, can protect the liver against cancer. The study, published online today in Developmental Cell, addresses a long-standing mystery in liver biology and could stimulate new ideas to prevent cancer.
Most human cells are diploid, carrying only one set of matched chromosomes that contain each person’s genome. Polyploid cells carry two or more sets of chromosomes. Although rare in most human tissues, these cells are prevalent in the hearts, blood, and livers of mammals. Polyploidization also increases significantly when the liver is exposed to injury or stress from fatty liver disease or environmental toxins that could cause liver cancer later in life. It is unknown, however, whether these increases in polyploidization have functional importance.
Previous research into the exact function of polyploid liver cells has been limited, in part because it has been difficult to change the number of sets of chromosomes in a cell, or ploidy, without introducing permanent mutations in genes that may also affect other cellular activities, such as division, regeneration, or cancer development. Because of this, there were many ideas as to why the liver is polyploid, but little experimental evidence.
CRI researchers have discovered a new approach.
“Our lab has developed new methods to transiently and reversibly alter ploidy for the first time. This was an important advance because it allowed us to separate the effects of ploidy from the effects of genes that change ploidy. Using these techniques, we were able to show polyploid liver cells protected the liver against cancer formation in the mouse,” said Dr. Hao Zhu, assistant professor at CRI and a CPRIT scholar in Cancer Research.
Surprisingly, livers with more polyploid cells do not have problems regenerating after various injuries.
These findings challenge a long-held concept that polyploidy is generally a pro-cancer state. They suggest instead, that it could be an adaptive response within normal liver cells. In humans, cancer develops when genes that suppress cancer, known as tumor suppressors, are lost and when mutations or genes that promote cancer, known as oncogenes, are gained or activated.
“We found polyploidy in liver cells did not strongly affect the activity of some oncogenes, but it did protect against the loss of tumor suppressor genes. When normal diploid cells lose one or both copies of tumor suppressor genes, cancers can form. Polyploid cells, which carry additional copies of important tumor suppressor genes, are better protected and more resistant to cancer formation because they have these extra copies of the genome,” said Dr. Zhu, who is also an assistant professor of pediatrics and internal medicine at UT Southwestern.
Future work in the Zhu lab will focus on the role of polyploidy in a variety of chronic liver diseases that frequently lead to liver cancer.
-
Exclusive Write-ups & Webinars by KOLs
-
Daily Quiz by specialty
-
Paid Market Research Surveys
-
Case discussions, News & Journals' summaries